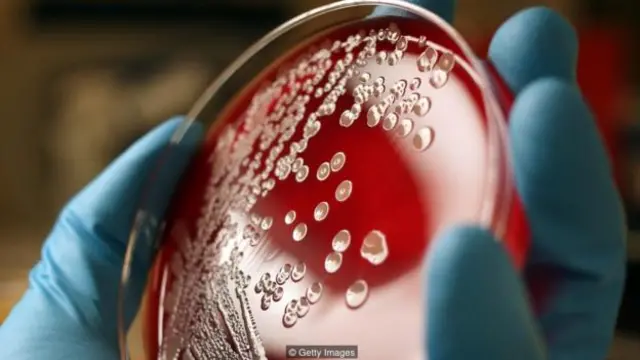
每个指尖上可发现数以千万计的细菌。(图片来源: Getty Images)

指甲缝下面有什么?

图像来源, Getty
大家都知道勤洗手是防止细菌传播的最佳途径。在许多地方,公共卫生法律规定从事食品餐饮服务行业的人员必须要确保他们的双手清洁。而事实上无论洗多少次手也无法彻底的洗掉手上的细菌。
由于不可能做到完全消毒,这也是医护人员在跟病患接触时为什么常常佩戴橡胶手套的原因所在。事实上,在一百多年前医生们就开始意识到,无论经过多少次洗涤,手上仍然能够检测出细菌。但是直到20世纪70年代初,研究人员才确认了手部细菌之所以洗不净的真正原因。
研究发现覆盖指尖可以使双手洁净的时间保持更久。而事实上并不是指尖上充满了细菌,而是指甲。指甲是一些薄的角质层,由类似犀牛角或羚羊角的物质形成,而指甲下面才是真正藏污纳垢的地方。
直到20世纪80年代末,科学家们才开始研究我们手指甲下面的物质。1988年,美国宾夕法尼亚大学皮肤学系(University of Pennsylvania’s Department of Dermatology)的三名研究人员进行了一项研究,他们用棉棒从26名成年志愿者手上取样,这些志愿者都是大学医学院的雇员,并从未参与病人护理。

研究发现,指甲下面的空间,又称为指(趾)甲下区域,是窝藏细菌的“重要场所”。研究人员在志愿者们手部的其他地方都发现了成千上万的细菌,而单个指甲的甲下区就藏有了成百上千万的细菌。研究人员在这两个区域中都发现了相同类型的细菌,而甲下区的细菌数量则更多。
研究人员认为,指甲与皮肤之间的甲床区域,由于有指甲的阻隔与潮湿的环境,为微小生物的滋生提供了良好的环境。之前的研究表明,反复冲洗仍不能清除手上的细菌,此次研究又发现甲下区藏有大量细菌,这两者的结合表明手上的这部分区域在普通的清洁中无法接触到抗菌药物。
想想看:我们用防止疾病传播的最好的办法也无法清洁你指甲下的空间。
事实上,一项发展迅速的研究对护士的手指甲上的微生物进行持续不断的研究。此项研究不仅仅局限于天然指甲,还包括人工指甲,和涂了指甲油的指甲。
1989年,仅在宾夕法尼亚大学的研究公布一年后,一些护士们写道,“虽然有关人工指甲和安全性和实用性的问题尚悬而未决,许多医务工作者已经受流行趋势影响,开始使用人造指甲”。
人工指甲往往比天然指甲长,且总是涂着甲油。研究人员试图查明佩戴人工指甲的56名护士是否会比天然指甲的56名护士指甲上的细菌更多。同时他们也希望了解到洗手对于那些带有人造指甲的人是否有效。
他们发现,带有人工指甲的护士无论洗手前后都比天然指甲的护士手上的细菌更多。这并不一定导致他们传播给病人的细菌更多,而是说他们手上的细菌更多。而细菌的存在至少增加了潜在的病原体传播的可能性。
2000年和2002年的类似的研究也取得了同样的结果。但那时,护理科研人员有证据表明佩戴人工指甲常和不勤洗手这样的习惯相联系,而这只会使问题复杂化。研究还表明人造指甲也更容易损坏一次性手套。

涂指甲油的天然指甲则存在另外一个问题。细菌容易藏在甲油上的微小裂缝中。1993年,位于巴尔的摩的约翰斯霍普金斯医院(Johns Hopkins Hospital)的护士研究了26名人受雇于医院的,但不参与病人护理的成年女性。他们指甲普遍较短,并在涂甲油前和四天之后分别进行了取样检测。
涂指甲油的天然指甲和涂指甲油的人工指甲下面的细菌微生物多样性方面没有任何变化,但是,“保持指甲短而干净,比是否涂指甲油更重要,”研究人员总结到。第二年进行的另一项研究得出了类似的结论。涂指甲油四天后手上的细菌比刚涂指甲油之后的要多。
全球每年有两到三百万人死于腹泻;而勤用肥皂洗手可以使大约100万人免于死亡。这个方法或许是有效的,但是除了洗手之外,最好的办法就是要注意指甲的甲下区的清洁问题,而最不容易藏匿污垢的办法就是要保持手指甲短而干净。
如果你还不能改掉咬指甲的癖好的话,那么以上这些问题值得你认真的思考。
请访问 <link type="page"><caption> BBC Future</caption><url href="http://www.bbc.com/future" platform="highweb"/></link> 阅读 <link type="page"><caption> 英文原文</caption><url href="http://www.bbc.com/future/story/20160622-what-lives-under-your-fingernails" platform="highweb"/></link>。